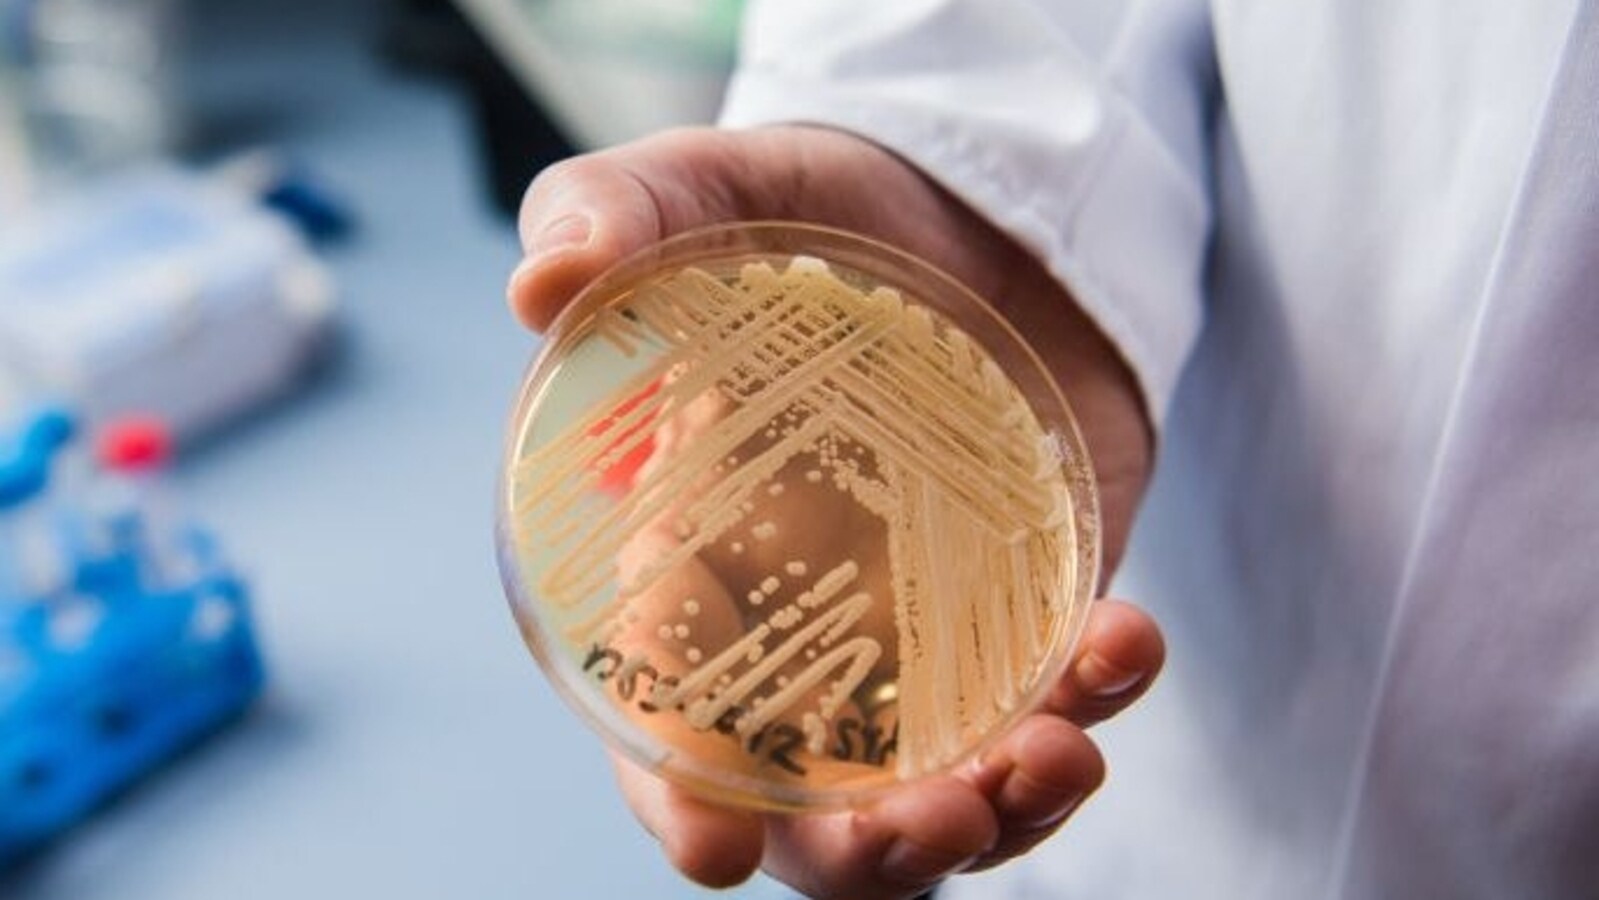

"Seattle's First Outbreak of Deadly Candida Auris Fungus"
Candida auris, a rare and deadly fungal infection, has caused concerns in the United States with recent cases reported in Washington. The infection, often resistant to antifungal medications, poses a significant threat, especially in healthcare facilities, and can lead to severe disease with a high mortality rate. Symptoms include fever, chills, and body aches, and treatment involves antifungal medications, although limited efficacy and potential for resistance development complicate therapeutic interventions. Management strategies focus on stringent infection control measures within healthcare settings to prevent its spread.